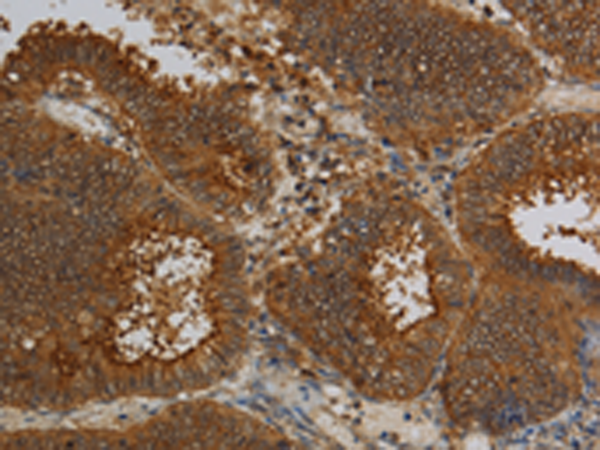

別 名: TALK2; TASK4; TALK-2; TASK-4; K2p17.1
技術規(guī)格
|
WB Recommended dilution: |
200-1000 |
|
WB Positive control: |
LO2 cells |
|
WB Predicted band size: |
37 kDa |
|
IHC Recommend dilution: |
100-300 |
|
IHC positive control: |
Human colon cancer and Human thyroid cancer |
|
ELISA Recommended dilution: |
1000-2000 |
|
SwissProt: |
Q96T54 |
|
Synonyms: |
TALK2; TASK4; TALK-2; TASK-4; K2p17.1 |
|
Full name: |
potassium channel, subfamily K, member 17 |
|
Immunogen: |
Fusion protein of human KCNK17 |
|
Name of antibody: |
KCNK17 |
|
Applications: |
ELISA, WB, IHC |
|
Background: |
The protein encoded by this gene belongs to the family of potassium channel proteins containing two pore-forming P domains. This channel is an open rectifier which primarily passes outward current under physiological K+ concentrations. This gene is activated at alkaline pH. Alternatively spliced transcript variants encoding different isoforms have been found for this gene. |

購物車
購物車 幫助
幫助
 021-54845833/15800441009
021-54845833/15800441009
